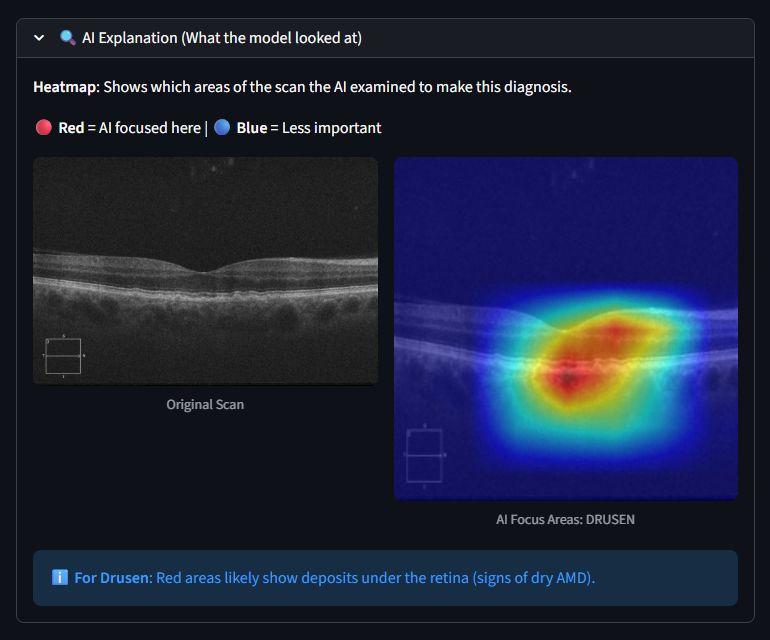
Oct Insight screenshot 2
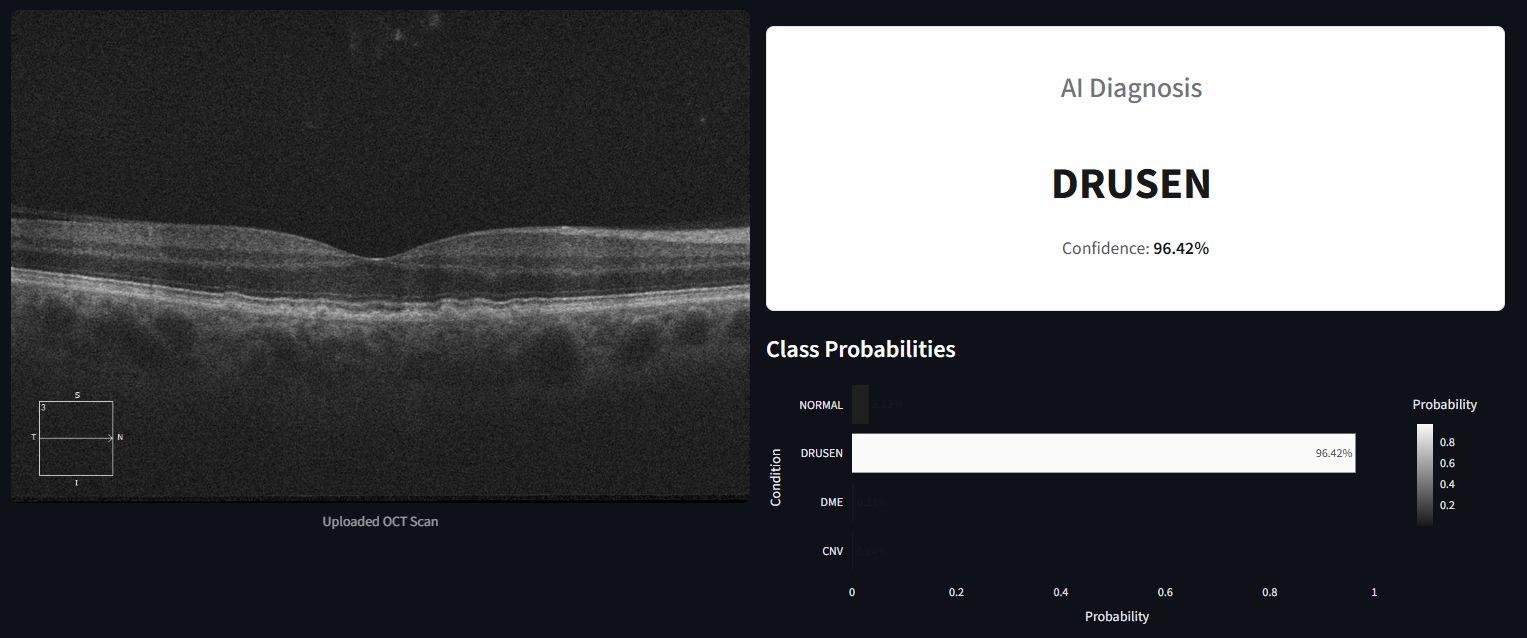
Oct Insight screenshot 1

O
Screenshots

About
Oct Insight is an AI-powered web application for classifying retinal diseases from Optical Coherence Tomography (OCT) scans. Built on a ResNet50 deep learning model trained on over 84,000 OCT images, it can identify four retinal conditions (CNV, DME, Drusen, and Normal) with high accuracy. The app features Grad-CAM explainability heatmaps that highlight the regions the model focuses on, along with confidence score visualizations for each prediction. Running entirely in-browser via Streamlit Cloud, no installation or account is required.
Features
- AI classification of 4 retinal conditions: CNV, DME, Drusen, and Normal
- ResNet50 deep learning model trained on 84,000+ OCT images
- Grad-CAM heatmaps for explainable AI predictions
- Confidence score visualization for each diagnosis
- Upload and analyze OCT scans instantly in your browser
- No installation or account required. Runs on Streamlit Cloud
- Research and educational tool for retinal disease analysis